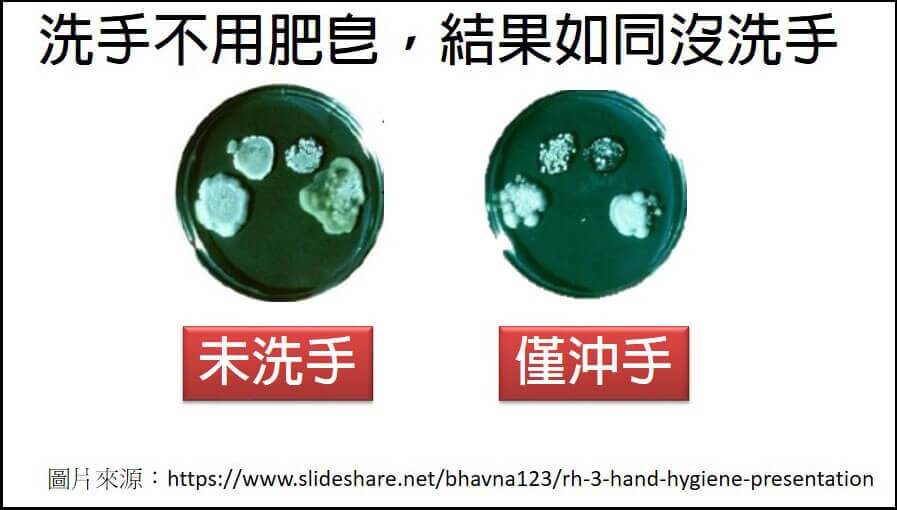

洗手少了擦乾這一步,細菌反而增加8成

濕度過高或過低,流感病毒更活耀
有效預防流感,除了正確洗手戴口罩,別忘了「監控濕度」也很重要!流感的傳染途徑,主要是透過感染者咳嗽或打噴嚏所產生的飛沫將病毒傳播給其他人,尤其在密閉空間,由於空氣不流通,更容易造成病毒傳播。另外,因為流感病毒可在低溫潮濕的環境中存活數小時,故可短暫存活於物體表面,所以也可經由接觸傳染,如手接觸到污染物表面上的口沫或鼻涕等黏液,再碰觸自己的口、鼻或眼睛而感染。
根據2013年美國的研究發現,室內(約20℃)濕度會影響A型流感病毒的傳染力,濕度控制在40%~60%,病毒較不利傳播,傳染力自然較低。
洗手五步驟「濕搓沖捧擦」的科學秘密,你一定要知道!
大家都知道要戴口罩和勤洗手來預防流感,偏偏冬天天冷是大人小孩最不愛碰水的季節,尤其小孩,洗手搓個兩三下就跑走(雖然夏天也不一定乖乖洗手),這其實跟沒洗手沒兩樣,因為手上的菌落幾乎不會被沖掉。可以參考下圖,研究者分別在洗手前和沖水後,蓋手印於培養皿上,幾天後發現,培養皿上的菌落,僅沖水雖然較未洗手少些,但其實差異不大。
如果是使用肥皂洗手,或甚至酒精消毒,那結果就不相同了,很明顯的,光用肥皂洗手就能帶走大多數的菌落,使用酒精消毒,更能徹底清潔。



